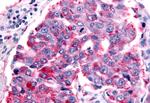
PTGER1 Antibody in Immunohistochemistry (Paraffin) (IHC (P))

Search
Invitrogen
PTGER1 Polyclonal Antibody
{{$productOrderCtrl.translations['antibody.pdp.commerceCard.promotion.promotions']}}
{{$productOrderCtrl.translations['antibody.pdp.commerceCard.promotion.viewpromo']}}
{{$productOrderCtrl.translations['antibody.pdp.commerceCard.promotion.promocode']}}: {{promo.promoCode}} {{promo.promoTitle}} {{promo.promoDescription}}. {{$productOrderCtrl.translations['antibody.pdp.commerceCard.promotion.learnmore']}}
产品信息
PA5-34118
种属反应
宿主/亚型
分类
类型
抗原
偶联物
形式
浓度
规格
纯化类型
保存液
内含物
保存条件
运输条件
RRID
产品详细信息
Percent identity with other species by BLAST analysis: Human, Gorilla, Monkey, Marmoset, Hamster, Bovine, Dog (94%) Mouse, Rat, Bat (81%).
靶标信息
The protein encoded by this gene is a member of the G protein-coupled receptor family. This protein is one of four receptors identified for prostaglandin E2 (PGE2). Through a phosphatidylinositol-calcium second messenger system, G-Q proteins mediate this receptor's activity. Knockout studies in mice suggested a role of this receptor in mediating algesia and in regulation of blood pressure. Studies in mice also suggested that this gene may mediate adrenocorticotropic hormone response to bacterial endotoxin.
仅用于科研。不用于诊断过程。未经明确授权不得转售。
篇参考文献 (0)
生物信息学
蛋白别名: G-protein coupled receptor; PGE receptor EP1 subtype; PGE receptor, EP1 subtype; PGE2 receptor EP1 subtype; prostaglandin E receptor 1 (subtype EP1), 42kD; prostaglandin E receptor 1 (subtype EP1), 42kDa; prostaglandin E receptor 1, subtype EP1; Prostaglandin E2 receptor EP1 subtype; Prostanoid EP1 receptor
基因别名: EP1; PTGER1
UniProt ID: (Human) P34995
Entrez Gene ID: (Human) 5731